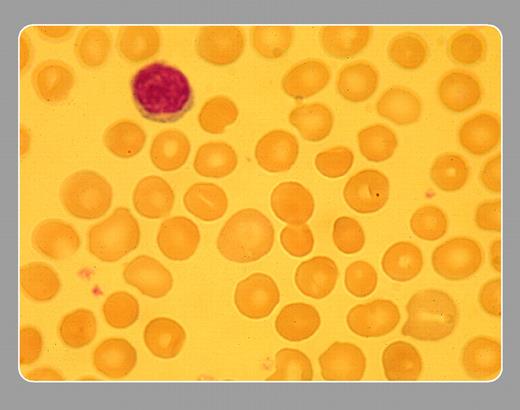
Stanley Schrier, Stanford University School of Medicine

Topics:
hereditary spherocytosis
This smear is from a patient with hereditary spherocytosis. Note the dense microspherocytes with absent central pallor. Because of an inherited abnormality in structural red cell membrane proteins, the red cell sheds microparticles such that the membrane loses surface area. The result is that the red cell can no longer maintain its biconcave disc shape and becomes more spherocytic, a shape that jeopardizes passage of affected RBCs from the splenic cords into the sinuses.FIG1
The above image was first published in the ASH IMAGE BANK, a reference and teaching tool that is continually updated with new atlas images and images of case studies. For more information or to contribute to the Image Bank, visit www.ashimagebank.org.
Copyright © 2004 by The American Society of Hematology
2004
Stanley Schrier, Stanford University School of Medicine
This feature is available to Subscribers Only
Sign In or Create an Account Close Modal